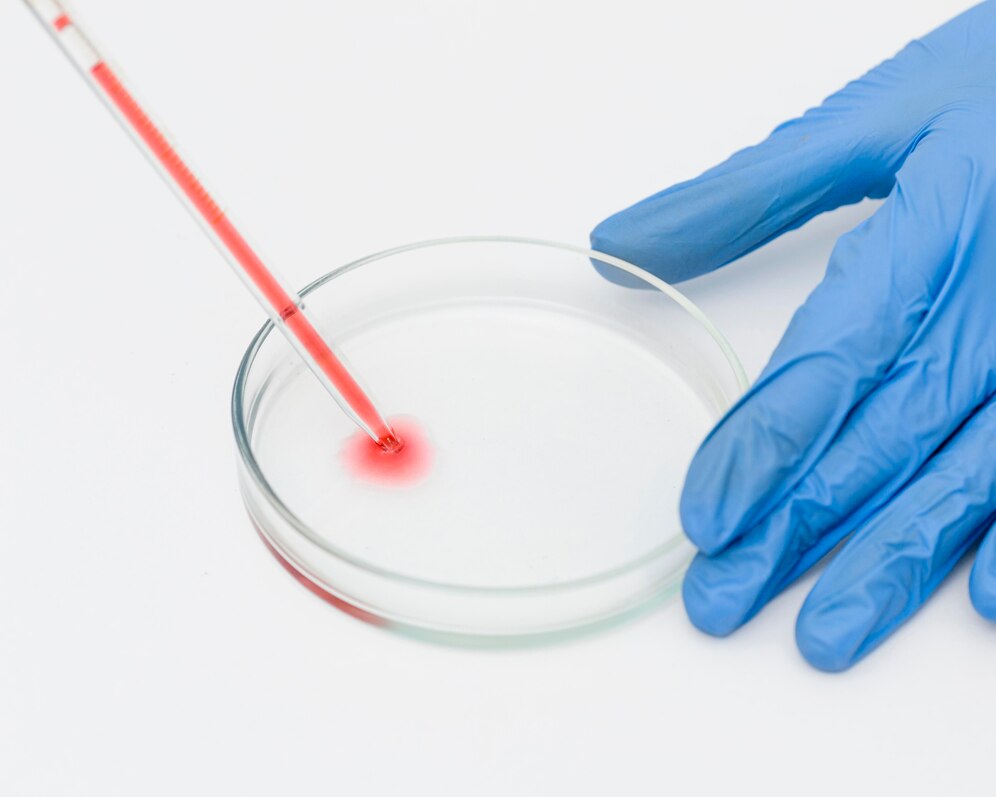

OTHER TESTING FACILITIES
OTHER TESTING FACILITIES

Nutritional Value Testing Lab
We offer precise nutritional value testing services to analyze the composition of food and bevera


Pathogen Testing
We offer reliable pathogen testing services to detect harmful microorganisms in food, beverages,

Sterility Testing
We provide accurate sterility testing services to ensure the safety and quality of pharmaceutical
Bacterial Endotoxin Testing (BET)
Bacterial Endotoxin Testing (BET)
We provide precise Bacterial

Pesticide Residue Testing
We provide comprehensive pesticide residue testing services to ensure the safety and quality of f

Heavy Metals Testing
We offer reliable heavy metals testing services to detect toxic metals such as lead, arsenic, mer

Adulterants Testing
We provide comprehensive adulterants testing services to detect and identify harmful substances i

Paper, Pulp & Plastics Testing
We provide comprehensive testing services for ores and minerals to assess their composition, qual

Ores & Minerals
We offer specialized testing services for plastics and resins to evaluate their composition, qual

Plastic & Resins Testing
At Jagdamba Laboratories, we provide specialized testing services for plastics and resins

Oil seeds & by products
At Jagdamba Laboratories, we specialize in testing oil seeds and their b


Plastics & polymers
At Jagdamba lab, we offer a wide range of plastics and polymer materials
